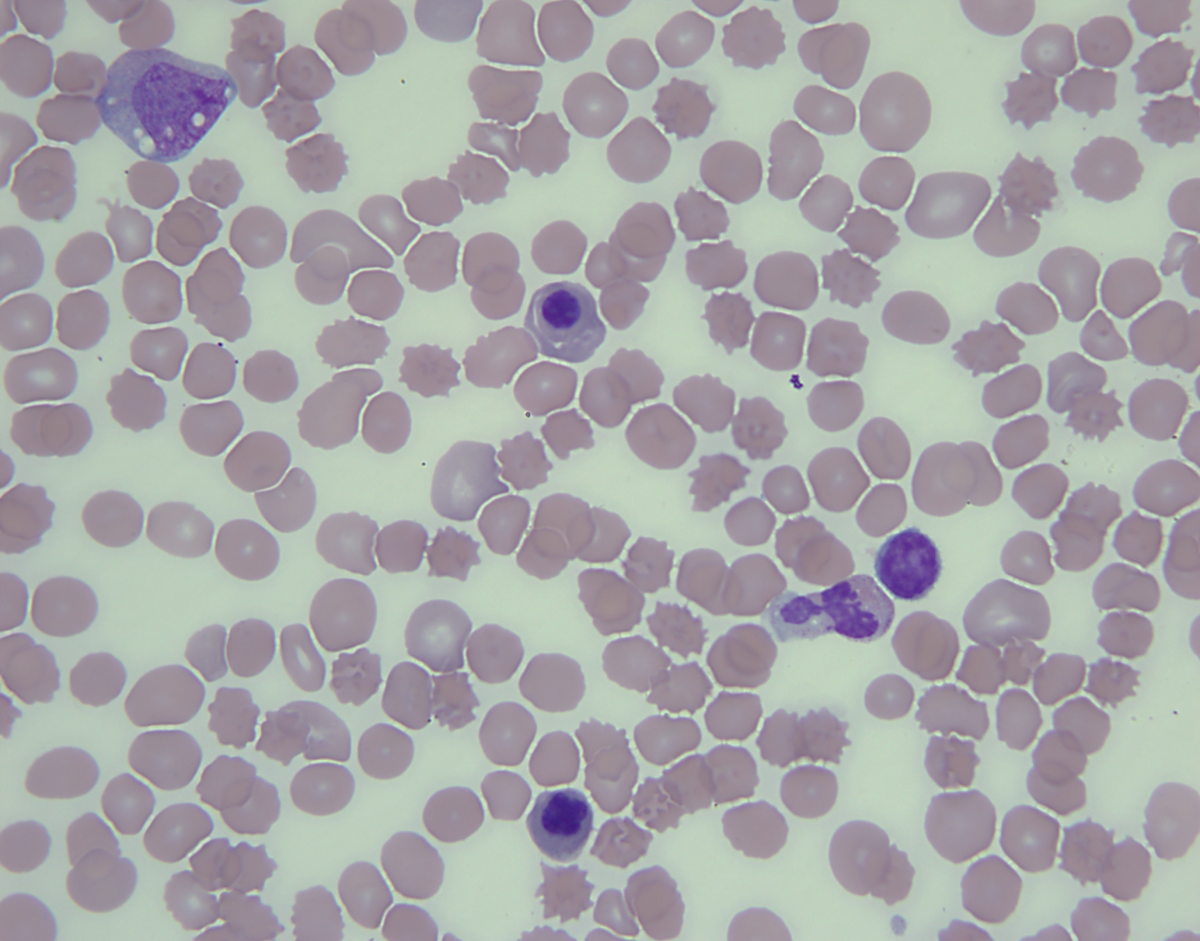
Peripheral blood, 100X
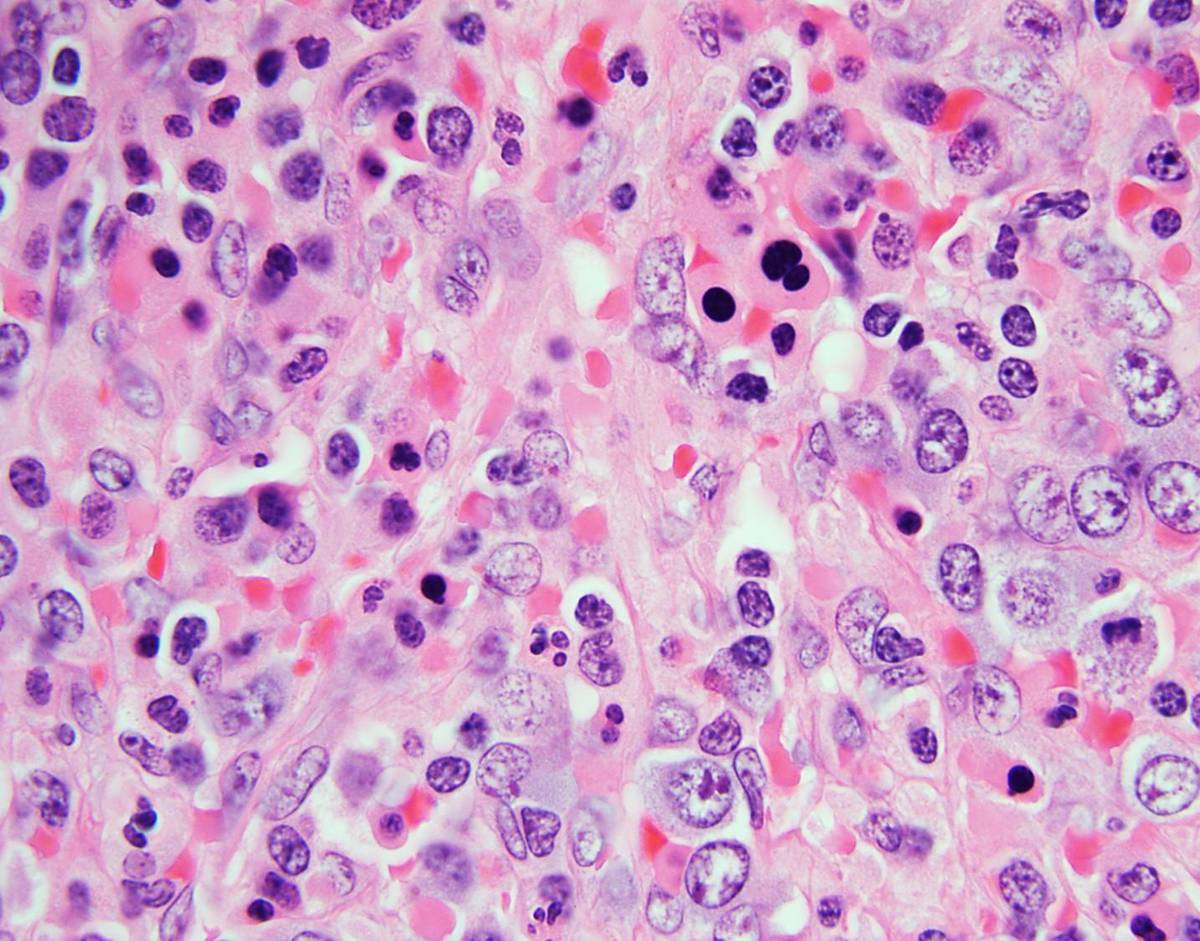
Spleen, 100X

Institution: Columbia University Medical Center, New York, NY
Additional authors:Bachir Alobeid, MD, Govind Bhagat, MBBS, Daniela Hoehn, MD, PhD
Session: AML with myelodysplasia-related changes
HISTORY
5 month-old female with Noonan syndrome (PTPN11 mutation positive) and hypertrophic cardiomyopathy with multiple anatomic defects, admitted to pediatric ICU after cardiac catheterization and respiratory arrest to await transplant. Hospitalization was complicated by recurrent infections, febrile episodes and increasing white blood cell count with 1% myeloblasts by flow cytometry. Physical exam showed severe hepatosplenomeglay. Labs: CBC: WBC: 20.2, Hb: 9.7, Platelets: 249, (Differential: absolute monocytosis (3.4 x 10^9/L), absolute lymphocytosis (5.8 x 10^9/L), 1% myelocytes, 5% bands, and nucleated RBC’s 1.9/100WBC) Patient received supportive care and underwent cardiac transplantation. 4 months post-transplant, platelet and PRBC transfusion requirement escalated. Respiratory failure worsened in part due to mass effect of markedly enlarged spleen. A splenectomy was performed for symptomatic relief.
DETAILS
Bone Marrow Examination Bone marrow core needle biopsy (left posterior iliac crest) was fixed in Bouin solution. Bone marrow aspiration was sent for morphological evaluation, cytogenetic analysis and flow cytometry. • Core needle biopsy (hematoxylin and eosin) demonstrated marked erythroid hyperplasia, dyserytropoiesis and patchy interstitial pockets of large mononucleated cells with oval to folded nuclei, irregular nuclei contour and abundant amount of amphophilic cytoplasm. Moderate reticulin fibrosis was noted (MF-2, European Myelofibrosis Network) • Wright- Giemsa stained aspirate smear were of limited quality demonstrating 3% myeloblasts, promonocytes, atypical monocytes and erythroid hyperplasia with significant dyserythropoiesis. No Auer rods were present. Splenectomy Splenomegaly: 12.6 x 5.0 x 3.0 cm, 137 gms. Unremarkable capsular surface and homogenously red and congested parenchyma. Representative sections submitted for flow cytometry, cytogenetics, molecular studies and permanent sections (formalin fixed/ paraffin embedded). • Hematoxylin and eosin (H&E) stained slides showed expanded red pulp with extensive and markedly left-shifted extramedullary hematopoiesis (EMH) consisting of a mixture of left-shifted erythropoiesis, left-shifted myelopoiesis, occasional megakaryocytes and rare blast cells. White pulp appeared decreased and morphologically unremarkable. • Wright-Giemsa stained touch preparations show extramedullary hematopoiesis with erythroid predominance showing dysplastic features. Scattered blasts were present, promonocytes and monocytes including atypical forms were identified. Remaining myeloid elements showed progressive maturation
IMMUNOHISTOCHEMISTRY AND FLOW CYTOMETRY
Bone Marrow Biopsy • IHC analysis: Blasts (3%) were positive for CD34, with a subset showing CD117 positivity. Marked erythroid hyperplasia was highlighted by E cadherin. • Flow cytometric analysis detected 1.1% myeloblasts, a minute population of hematogones and increased monocytes with a spectrum of maturation. Splenectomy • IHC analysis: CD34 highlighted rare blasts. CD61 highlighted rare megakaryocytes. Glycophorin A and E-cadherin showed erythroid elements. CD33/CD117 demonstrated left shifted myelopoiesis. CD20 demonstrated a relative decrease in white pulp. Increased CD56+ small lymphocytes were present. • Flow cytometric analysis detected immature precursor cells, as defined by CD34 or CD117 expression (3.4% and 6.1%, of gated events respectively).
CYTOGENETIC FINDINGS
Bone Marrow Biopsy: 46,XX[20]
Splenectomy: 46,XX[20].
Fluorescence in situ hybridization (FISH):
Negative for del(7q) (CEP7/D7S486 probe)
MOLECULAR FINDINGS
Bone marrow aspirate, KRAS Codon 12/13 ARMS-Scorpions Assay: negative.
INTERESTING FEATURES
JMML-like MPN in a patient with Noonan syndrome, PTPN11 mutation and prolonged monocytosis with erythroid hyperplasia, dyserythropoiesis and increased reticulin fibrosis in bone marrow and extramedullary hematopoiesis in spleen.
PROPOSED DIAGNOSIS
JUVENILE MYELOMONOCYTIC LEUKEMIA-LIKE MYELOPROLIFERATIVE NEOPLASM in normocellular bone marrow (>90%) with marked erythroid hyperplasia and dyserythropoiesis MODERATE RETICULIN FIBROSIS (MF-2, EUROPEAN MYELOFIBROSIS NETWORK).
CONSENSUS DIAGNOSIS
Juvenile myelomonocytic leukemia-like myloproliferative neoplasma with marked erythroid hyperplasia/dyspoiesis and myelofibrosis (MF-2), in a patient with Noonan syndrome/PTPN11 germline mutation
| Peripheral blood, 40X |  |
| Peripheral blood, 100X | |
| Bone marrow core biopsy, 10X |  |
| Bone marrow core biopsy, 40X |  |
| Bone marrow core biopsy, e-cadherin, 40X |  |
| Bone marrow core biopsy, reticulin stain, 40X |  |
| Bone marrow aspirate, Wright-Giemsa stain, 100X |  |
| Spleen, 20X |  |
| Spleen, 100X |  |
| Spleen, 100X | |
| Spleen, e-cadherin |  |
| Spleen, CD117, 40X |  |
| Spleen, Wright-Giemsa stained touch preparation, 40X |  |
| Spleen, Wright-Giemsa stained touch preparation, 100X |  |